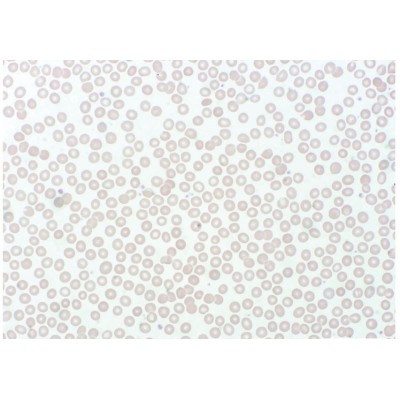
Preparación microscópica Jeulin LN-575406. Sangre humana

Inicio
Filtrar por
Subcategorías
-
Ciencias naturales
En Pidiscat puedes escojer entre una gran variedad de material relacionado con el estudio de las ciencias naturales, tanto consolas de adquisición de datos Easysense, como material fungible como portaobjetos, cubreobjetos, lupas de mano o prismáticos.
-
Microscopía
Pidiscat ofrece un amplio abanico de productos dentro del área de la Microscopía: microscopios y estereomicroscopios (lupas binoculares) de diferentes niveles (básicos, superiores, profesionales, investigación...) y también diferentes accesorios como cámaras digitales de microscopía, fundas, maletas, portaobjetos y muchos más.
-
Geología
Pidiscat vende varios productos como cajas de minerales, rocas y una variedad de brújulas destinados a dar un uso académico en el campo de Geología.
-
Meteorología
En Pidiscat puedes comprar una variedad de productos relacionados con la Meteorología: termómetros, barómetros, estaciones meteorológicas, etc.
-
Biología
Pidiscat ofrece una série de productos relacionados con el aprendizaje de la biologia. Contamos con modelos osteológicos, modelos anatómicos y murales de biología y anatomía, a parte de herramientas para realizar disecciones.
-
Microbiología
En Pidiscat puedes comprar varios productos relacionados con el estudio de la microbiología, como agar cromogénico, colorantes, caldos deshidratados, etc.
-
Física
En Pidiscat ofrecemos una ámplia gamma de productos destinados al estudio de la Física.
-
Química
En Pidiscat puedes comprar todo tipo de productos relacionados con el aprendizaje y experimentación de la Química en centros educativos.
-
Material auxiliar
Pidiscat ofrece material auxiliar como por ejemplo escobillones, gradillas, papeles filtro, etc. destinado al suporte del aprendizaje y experimentación de las ciencias en centros educativos.
-
Instrumentación
En Pidiscat puedes comprar material de suporte para la experimentación al laboratorio de centros escolares, como por ejemplo balanzas, incubadoras y estufas.
-
Productos químicos
-
Analítica
Pidiscat vende varios productos relacionados con la realización de pruebas analíticas, como por ejemplo tiras indicadoras y papeles reactivos.
-
Seguridad y protección
Disponemos de todo tipo de mobiliario de laboratorio y equipos de protección individual (EPI): mascarillas quirúrgicas, mascarillas desechables (FFP1, FFP2 y FFP3, con o sin válvula), mascarillas de filtro intercambiable, gafas de seguridad de cinta o varillas, pantallas faciales, guantes de diversos materiales (nitrilo, látex y vinilo), batas desechables (TST o plástico) y productos de higiene como geles hidroalcohólicos y papel de celulosa.
-
Audiovisuales
Pidiscat dispone de varios productos de suporte audiovisual como por ejemplo pantallas de proyección y equipos de sonido.
-
Tecnología
Pidiscat ofrece una variedad de productos relacionados con la tecnología, destinados a ser usados en las clases prácticas de la asignatura.
-
Matemáticas
En Pidiscat encontrarás productos que sirven de suporte en la enseñanza de las matemáticas en centros educativos.
-
Geografía
Pidiscat dispone de material como mapas y globos terráqueos destinado a la enseñanza de geografía en centros escolares.
-
Música
Pidiscat pone a tu disposición instrumentos de música para el aprendizaje de esta en los centros escolares.
-
Línea doméstica
-
Experimentación
-
Material volumétrico...
El material volumétrico de medición de laboratorio se compone de herramientas altamente precisas diseñadas para medir volúmenes líquidos con exactitud. Incluye elementos como buretas, pipetas volumétricas y matraces aforados. Estos instrumentos son calibrados meticulosamente para proporcionar mediciones precisas y repetibles de volúmenes líquidos específicos.
Se utilizan en situaciones en las que la precisión es fundamental, como en análisis cuantitativos y experimentos que requieren dosificaciones exactas. Las pipetas volumétricas miden y transfieren un volumen específico de líquido con gran precisión, mientras que los matraces aforados contienen un volumen preciso de líquido cuando se llena hasta una marca de aforo. Las buretas se emplean para dispensar líquidos con una precisión extrema en titulaciones y valoraciones. El material volumétrico de medición es esencial para asegurar resultados confiables y reproducibles en procedimientos de laboratorio que dependen de mediciones precisas de volúmenes. -
Material volumétrico...
El material volumétrico aproximado de laboratorio consiste en instrumentos diseñados para medir volúmenes de líquidos con un grado aceptable de aproximación. Incluye elementos como matraces graduados y pipetas graduadas. Aunque no ofrecen la misma precisión que el material volumétrico de precisión, son útiles para mediciones cercanas a un valor específico.
Este material es valioso en situaciones donde la exactitud precisa no es esencial, pero se requiere un volumen aproximado de líquido para llevar a cabo experimentos, reacciones y preparaciones. Por ejemplo, los matraces graduados son adecuados para medir volúmenes aproximados de líquidos, mientras que las pipetas graduadas se utilizan para dispensar cantidades cercanas a un valor determinado. Aunque no proporcionan la misma precisión que el material volumétrico de precisión, el material volumétrico aproximado es una opción eficiente y práctica para muchas aplicaciones en el laboratorio. -
Material complementario
-
Catálogo
-
Archivadores...
Los archivadores portaobjetos para microscopios son sistemas de almacenamiento diseñados para organizar y proteger portaobjetos con muestras preparadas. Estos archivadores cuentan con ranuras individuales donde se pueden colocar los portaobjetos de manera ordenada, evitando daños y contaminación. Son esenciales para mantener la integridad de las muestras y facilitar un acceso rápido y eficiente a ellas durante observaciones microscópicas y análisis posteriores en el laboratorio. -
cientifica
-
Accesorios